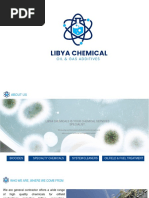

Data Science Lab
Matplotlib
DataBase and Data Mining Group Andrea Pasini, Elena Baralis
Matplotlib introduction
▪ Two of the most commonly used graphical
libraries are:
▪ Matplotlib
▪ We present here only a very short introduction as the
library is huge and visualization is not the focus of this
course
▪ Seaborn (data visualization library based on
Matplotlib)
▪ Not covered by this course
2
Matplotlib introduction
▪ Matplotlib
▪ Set of methods that make matplotlib work like matlab
▪ It has 2 interfaces:
▪ Matlab style plotting (Stateful)
• Plotting methods are called from the pyplot package
• They all work on the current Figure and Axes
▪ Object oriented (Stateless) <-- Use this one
• Plot functions are called as methods of a specific
Figure and Axes
• This allows modifying many objects at a time (the
system does not keep a “current object” state)
3
Matplotlib introduction
▪ Figures and Axes
Figure
Axes Axes
y_axis x_axis
4
Matplotlib introduction
▪ Creation of a new figure:
import matplotlib.pyplot as plt
fig, ax = plt.subplots(figsize=(5, 3))
plt.show()
▪ Subplots returns a new Figure and its Axes object
▪ figsize specifies the figure size (width, height) in
inches
▪ By default ax is a single Axes object (Figure with 1
single)
5
Matplotlib introduction
▪ Creation of a new figure:
fig, ax = plt.subplots(2, 3, figsize=(5, 3))
plt.tight_layout()
plt.show()
▪ The first two parameters of subplots specify to create
a figure with 2 rows, 3 columns (6 Axes objects)
▪ tight_layout() is necessary at the end to let the
subplots fit the frame size without blank spaces at the
borders
6
Matplotlib introduction
▪ Drawing a line plot (single Axes object)
fig, ax = plt.subplots(figsize=(3, 2))
ax.plot([0,1,2],[2,4,6])
ax.plot([0,1,2],[3,6,9])
plt.show()
▪ The plot method of a specific Axes takes as input two
lists (or Numpy arrays): x, y coordinates of the points
▪ The default style draws segments passing through
the specified coordinates
▪ Subsequent calls of plot add new line to the same
Figure
7
Matplotlib introduction
▪ Drawing a line plot (multiple Axes object)
fig, ax = plt.subplots(1, 2,
figsize=(3, 2))
ax[0].plot([0,1,2],[2,4,6])
ax[1].plot([0,1,2],[3,6,9])
plt.tight_layout()
plt.show()
▪ The ax object is a Numpy array with the created
Axes objects
▪ It has shape = (n, ) if the figure has 1 row and n
columns
8
Matplotlib introduction
▪ Drawing a line plot (multiple Axes object)
fig, ax = plt.subplots(2, 2,
figsize=(3, 2))
ax[0, 0].plot([0,1,2],[2,4,6])
ax[1, 1].plot([0,1,2],[3,6,9])
plt.tight_layout()
plt.show()
▪ It has shape = (m, n) if the figure has m rows and n
columns
9
Plot types
▪ With Matplotlib you can design different plot types
▪ The most common are:
▪ Line plot
▪ Scatter plot
▪ Bar chart
10
Line plot
▪ Allows displaying a sequence of points/segments
that share the same properties
▪ E.g. same size, color, width, ...
x = np.linspace(0, 5, 20)
y = np.exp(x)
fig, ax = plt.subplots(figsize=(3, 2))
ax.plot(x, y, c=‘blue’, linestyle=‘’, marker=‘*’)
ax.plot(x, 2*y, c=‘green’, linestyle=‘--’)
plt.show()
11
Line plot
▪ Different plots can be associated to labels to be
displayed in a legend
x = np.linspace(0, 5, 20)
y = np.exp(x)
fig, ax = plt.subplots(figsize=(3, 2))
ax.plot(x, y, c=‘blue’, linestyle=‘’, marker=‘*’, label=‘curve 1’)
ax.plot(x, 2*y, c=‘green’, linestyle=‘--’, label=‘curve 2’)
ax.legend(loc=(1.1, 0.5))
plt.show()
12
Line plot
▪ linestyle specifies the type of line
▪ Examples: ‘-’, ‘--’ (or ‘dashed’), ‘:’ (or ‘dotted’)
▪ marker specifies the type of points to be drawn
▪ Examples: ‘o’, ‘*’, ‘+’, ‘^’
▪ c specifies the color to be applied to markers and
segments
▪ Examples: ‘red’, ‘orange’, ‘grey’
▪ Examples: ‘#0F0F6B’ (RGB)
▪ Examples: (0.5, 1, 0.8, 0.8) (RGBA tuple)
13
Scatter plot
▪ Allows displaying a set of points and assign them
custom properties
▪ E.g. different color, size
x = np.random.rand(20)
y = np.random.rand(20)
colors = x + y # color as a function of x and y
fig, ax = plt.subplots(figsize=(3, 2))
ax.scatter(x, y, c=colors)
plt.show()
14
Scatter plot
▪ c=colors associate a number (float or integer) to
each point
▪ In the same sequence as they appear in x, y)
▪ These numbers are used to select a color from a
specific colormap
▪ https://matplotlib.org/users/colormaps.html
colors = x + y # color as a function of x and y
fig, ax = plt.subplots(figsize=(3, 2))
ax.scatter(x, y, c=colors, cmap=‘spring’)
plt.show()
15
Scatter plot
▪ c=colors associate a number (float or integer) to
each point
▪ Matplotlib considers the range of values of c to fit the
whole range of colors of a colormap
▪ c = [101, 120, 50, 60] -> range is 50-120
50 120
16
Scatter plot
▪ The size of each point can be set with the
parameter s
▪ Size is the area in dpi
x = np.random.rand(20)
y = np.random.rand(20)
colors = x + y # color as a function of x and y
area = 100*(x+y) # size as a function of x, y
fig, ax = plt.subplots(figsize=(3, 2))
ax.scatter(x, y, c=colors, s=area)
plt.show()
17
Bar chart
▪ Allows displaying a sequence of numbers as
vertical or horizontal bars
height = [10, 2, 8]
x = [1, 2, 3] # position of the bars, x axis
fig, ax = plt.subplots(figsize=(3, 2))
ax.bar(x, height)
plt.show()
18
Bar chart
▪ Ticks on the horizontal axis can be labeled with
some text
height = [10, 2, 8]
x = [1, 2, 3] # position of the bars, x axis
labels = ['Sensor 1', 'Sensor 2', 'Sensor 3']
fig, ax = plt.subplots(figsize=(3, 2))
ax.bar(x, height, tick_label=labels)
plt.show()
19
Bar chart
▪ Bars can be grouped
height_min = [10, 2, 8]
height_max = [8, 6, 5]
x = np.arange(3)
width = 0.4
labels = ['Sensor 1', 'Sensor 2', 'Sensor 3']
fig, ax = plt.subplots(figsize=(3, 2))
ax.bar(x+width/2, height_min, width=width, label='min')
ax.bar(x-width/2, height_max, width=width, label='max')
ax.set_xticks(x) # setup positions of x ticks
ax.set_xticklabels(labels) # set up labels of x ticks
ax.legend(loc=(1.1, 0.5)) # x, y position, in percentage
plt.show()
20
Writing images to file
▪ Generated figures can be saved to file with
different formats
fig, ax = plt.subplots(figsize=(3, 2))
ax.plot([0,1,2],[2,4,6])
ax.plot([0,1,2],[3,6,9])
fig.savefig(“./out/test.png") # or ‘.jpg’ or ‘.eps’
21
Seaborn
▪ Based on Matplotlib
▪ High level interface for
drawing complex chart with
attractive visual impact
22
References
▪ Matplotlib website:
▪ https://matplotlib.org/
▪ Seaborn website:
▪ https://seaborn.pydata.org/
23